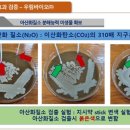

우림농장 - 서산시 총63명이 열람하였으며, 0개의 리뷰가 있습니다.
- 번호
- 54,120
- 개방서비스명
- 가축사육업
- 개방서비스아이디
- 02_04_01_P
- 개방자치단체코드
- 4,530,000
- 관리번호
- 453,000,003,320,200,026
- 인허가일자
- 2020-09-28
- 영업상태구분코드
- 1
- 영업상태명
- 영업/정상
- 상세영업상태코드
- 0
- 상세영업상태명
- 정상
- 소재지전체주소
- 충청남도 서산시 고북면 용암리 ***-***
- 도로명전체주소
- 충청남도 서산시 고북면 매령길 **-**
- 도로명우편번호
- 32,026
- 사업장명
- 우림농장
- 최종수정시점
- 2020-09-28 09:11:04
- 데이터갱신구분
- I
- 데이터갱신일자
- 2020-09-30 00:23:11
- 좌표정보x(epsg5174)
- 127
- 좌표정보y(epsg5174)
- 37
- 축산업무구분명
- 가축사육업
- 축산일련번호
- 1,586
- 권리주체일련번호
- 0
- 주사육업종
- 한우
- 전화번호
- 063-533-2001
주변 목록
클목장
충청남도 서산시 고북면 용암리 ***-** 외 *필지
'우림농장'에서 0.1km
충청남도 서산시 고북면 용암리 ***-** 외 *필지
바로가기
용암농장
충청남도 서산시 고북면 용암리 ***번지
'우림농장'에서 0.2km
충청남도 서산시 고북면 용암리 ***번지
바로가기
서광농장
충청남도 서산시 고북면 용암리 ***
'우림농장'에서 0.3km
충청남도 서산시 고북면 용암리 ***
바로가기
정정교농장
충청남도 서산시 고북면 용암리 ***번지
'우림농장'에서 0.4km
충청남도 서산시 고북면 용암리 ***번지
바로가기
날새농장
충청남도 서산시 고북면 신상리 ***-*
'우림농장'에서 0.5km
충청남도 서산시 고북면 신상리 ***-*
바로가기
효철농장
충청남도 서산시 고북면 가구리 **-*
'우림농장'에서 0.5km
충청남도 서산시 고북면 가구리 **-*
바로가기
우리숲
충청남도 서산시 고북면 가구리 **-*
'우림농장'에서 0.6km
충청남도 서산시 고북면 가구리 **-*
바로가기
도간목장
충청남도 서산시 고북면 가구리 ***-**
'우림농장'에서 0.7km
충청남도 서산시 고북면 가구리 ***-**
바로가기
주변 동물 수입업
바나바스
충청남도 홍성군 금마면 화양리 ***-*
'우림농장'에서 17.9km
바로가기
㈜제이케이트레이드
충청남도 예산군 광시면 시목리 ***
'우림농장'에서 26.35km
바로가기
골든키티캐터리
충청남도 태안군 고남면 고남리 ****-*
'우림농장'에서 31.87km
바로가기
티랩스
충청남도 천안시 서북구 쌍용동 **** 연탄석쇠한판
'우림농장'에서 53.31km
바로가기
브이아이피독
경기도 화성시 서신면 매화리 ***-**
'우림농장'에서 55.62km
바로가기
삼성애견
충청남도 천안시 동남구 목천읍 삼성리 **-*
'우림농장'에서 56.92km
바로가기
주식회사 레스트시큐리티독
경기도 화성시 송산면 육일리 *** 포도마을 코스코밸리아파트
'우림농장'에서 59.63km
바로가기
스핑제리
경기도 화성시 마도면 쌍송리 *** 마도지구유통업무및지원시설
'우림농장'에서 60.27km
바로가기
KGBKENNEL(케이지비켄넬)
경기도 화성시 봉담읍 하가등리 ***-*
'우림농장'에서 63.19km
바로가기
쥬니멀
경기도 안산시 단원구 신길동 **** 리드 스마트스퀘어 지식산업센터
'우림농장'에서 74.5km
바로가기
(주)수달앤쥬
경기도 수원시 권선구 금곡동 ****-* 리더스빌딩
'우림농장'에서 75.46km
바로가기
특별한 동물가게
경기도 화성시 영천동 ***-*
'우림농장'에서 77.78km
바로가기
주변 동물 생산업
힐링애견
충청남도 서산시 고북면 신송리 ***
'우림농장'에서 3.98km
바로가기
미래펫
충청남도 서산시 해미면 동암리 ***-*
'우림농장'에서 6.45km
바로가기
서산벤지
충청남도 서산시 오남동 *-*
'우림농장'에서 8.4km
바로가기
오계절
충청남도 홍성군 갈산면 행산리 ***-*
'우림농장'에서 9.62km
바로가기
션샤인캣
충청남도 예산군 덕산면 낙상리 ***-*
'우림농장'에서 9.72km
바로가기
션샤인 캣터리
충청남도 예산군 덕산면 낙상리 ***-*
'우림농장'에서 9.72km
바로가기
프란체스코켄빌
충청남도 홍성군 홍북읍 중계리 ***-*
'우림농장'에서 10.63km
바로가기
라움캣
충청남도 홍성군 서부면 이호리 ***
'우림농장'에서 10.7km
바로가기
바론켄넬
충청남도 홍성군 결성면 형산리 ***-**
'우림농장'에서 11.37km
바로가기
늘봄
충청남도 홍성군 결성면 형산리 ***-*
'우림농장'에서 11.69km
바로가기
메인캣
충청남도 홍성군 홍북읍 상하리 ***
'우림농장'에서 11.73km
바로가기
반려켄넬
충청남도 홍성군 결성면 용호리 ***
'우림농장'에서 12.18km
바로가기
주변 동물용 의약품 도매상
주식회사 에이지동물약품
충청남도 예산군 삽교읍 신리 316-46
'우림농장'에서 12.01km
바로가기
동우동물약품
충청남도 홍성군 홍성읍 대교리 544
'우림농장'에서 14.71km
바로가기
푸른가축약품(주)
충청남도 홍성군 홍성읍 대교리 615
'우림농장'에서 14.81km
바로가기
대산가축약품
충청남도 홍성군 홍성읍 고암리 948
'우림농장'에서 14.97km
바로가기
(주)돼지와 건강
충청남도 홍성군 홍북읍 용산리 372 2동
'우림농장'에서 15.09km
바로가기
대도가축약품
충청남도 예산군 고덕면 대천리 725-4
'우림농장'에서 16.22km
바로가기
초원동물약품
충청남도 예산군 삽교읍 두리 805-4
'우림농장'에서 17.38km
바로가기
(주)에프브이씨
서울특별시 서초구 방배동 408
'우림농장'에서 19.56km
바로가기
녹십자수의약품(주)
충청남도 예산군 응봉면 주령리 408
'우림농장'에서 19.56km
바로가기
주식회사 우리동물약품
대전광역시 중구 중촌동 517-8
'우림농장'에서 21.15km
바로가기
유명동물약품
충청남도 홍성군 광천읍 광천리 237-17
'우림농장'에서 21.69km
바로가기
보령가축약품 유한회사
충청남도 보령시 천북면 하만리 260-17
'우림농장'에서 22.39km
바로가기
주변 동물 판매업
서산벤지
충청남도 서산시 오남동 *-*
'우림농장'에서 8.4km
바로가기
프란체스코켄빌
충청남도 홍성군 홍북읍 중계리 ***-*
'우림농장'에서 10.63km
바로가기
바론켄넬
충청남도 홍성군 결성면 형산리 ***-**
'우림농장'에서 11.37km
바로가기
스퀘어독스 서산점
충청남도 서산시 예천동 ***
'우림농장'에서 12.23km
바로가기
야옹아 멍멍해봐 강아지고양이 충남서산점
충청남도 서산시 동문동 ***-*
'우림농장'에서 12.54km
바로가기
티니펫
충청남도 서산시 동문동 ***-* 탑빌딩
'우림농장'에서 12.63km
바로가기
펫 & 쇼핑
'우림농장'에서 12.88km
바로가기
쇼독(Show dog)
충청남도 홍성군 홍북읍 신경리 ***
'우림농장'에서 13.09km
바로가기
show dog
충청남도 홍성군 홍북읍 신경리 ***
'우림농장'에서 13.09km
바로가기
한강아쿠아영어조합법인
충청남도 서산시 예천동 ***-**
'우림농장'에서 13.53km
바로가기
개최고
충청남도 홍성군 홍성읍 오관리 ***-*
'우림농장'에서 14.5km
바로가기
개 최고
충청남도 홍성군 홍성읍 오관리 ***-* 홍성숯불갈비
'우림농장'에서 14.5km
바로가기
주변 가축 인공 수정소
제너럴ET센터
충청남도 서산시 고북면 초록리 144-5
'우림농장'에서 2.08km
바로가기
충남한우협동조합 가축인공수정소
충청남도 서산시 해미면 읍내리
'우림농장'에서 3.45km
바로가기
강남가축인공수정소
충청남도 서산시 해미면 오학리 102-4번지
'우림농장'에서 4.63km
바로가기
합동가축인공수정소
충청남도 홍성군 갈산면 부기리 525번지
'우림농장'에서 8.07km
바로가기
하늘가축인공수정소
충청남도 예산군 덕산면 복당리 588-1번지
'우림농장'에서 8.31km
바로가기
갈산가축인공수정소
충청남도 홍성군 갈산면 상촌리 168-1번지
'우림농장'에서 8.93km
바로가기
운산가축인공수정소
충청남도 서산시 운산면 상성리 26번지
'우림농장'에서 9.96km
바로가기
낙원 한우 인공수정소
충청남도 서산시 운산면 원벌리 327
'우림농장'에서 9.96km
바로가기
농가
충청남도 예산군 덕산면 읍내리 360-2번지
'우림농장'에서 11.72km
바로가기
한우 수정소
충청남도 서산시 운산면 원평리 206-3
'우림농장'에서 12.1km
바로가기
구항가축인공수정소
충청남도 홍성군 구항면 황곡리 455
'우림농장'에서 12.65km
바로가기
선진 가축 인공수정소
충청남도 홍성군 홍성읍 월산리 520번지
'우림농장'에서 12.79km
바로가기
블로그 리뷰
-
이 포스팅은 쿠팡 파트너스 활동의 일환으로, 이에 따른 일정액의 수수료를 제공받습니다. 안녕하세요, 오늘 인스타에서 보다가 저장해놨던 열대우림 체험농장에 다녀왔어요. 원래 동물들을 좋아했어서 먹이체험은 무조건 하거든요! 너무 만족했던 곳 입니다. 위치 및 예약방법 열대우림 체험농장 경상남도 김해시...
아이와 나의 사계절(2026-04-04 18:11:00)

-
우림 체험농장에 다녀왔어요 결론부터 말하자면 아이있는 집이라면 한 번쯤 꼭!!! 가 볼만한곳!!! 부모도 아이도 만족한 곳이라 방문 후기 적어볼게요. 김해 열대우림 체험농장 주소: 경남 김해시 호계로300번길 154 운영시간: 매일 10시~ 17시까지 입장료 평일 어린이: 12,000원, 성인 6,000원 주말 어린이...
윤아윤호의 신나는 하루(2026-02-16 00:14:00)

-
지난 주말 그린파파가 출근을 해서 무얼해야하나.. 고민하다가 쌀쌀한데 실내체험장이 없을까? 서칭중에 눈에 띈 '김해 열대우림 체험농장'을 다녀왔습니다!! 사실 여긴 오픈했을 때 (여름쯤) 방문했었는데 너무 너무 너무 더웠던 기억에 발길을 멀리했던 곳이였답니다..ㅠㅠ 여름엔 에어컨 시원하게 켜주시는데도 비닐...
행복한 그린파파(2026-02-22 13:11:00)

-
주차 가능하며 따로 주차 관리인분은 안계신다 앞타임과는 10분 정도의 브레이크 타임이 있는데 시간대가 잘 못 맞으면 기다려야 할 수도 있으므로 체험시간을 위해 조금 일찍 도착하는것이 좋을 듯 하다 2. 열대우림 체험농장 가격 미리 예약이 필요한 곳으로 당일예약도 가능하다 (네이버에서 예약 가능) 네이버...
잠시 쉬어가는 곳(2026-01-10 23:12:00)

-
열대우림 체험농장 경상남도 김해시 호계로300번길 154 ⏰ 11:00-19:00 월요일 휴무 📞 0507-1486-1681 24개월 이하 무료 성인 8,000 (평일 6,000) 어린이 15,000 (평일 12,000) 김해 실내로 가볼만 한 열대우림 체험농장 추운겨울에 실내로 체험하기 딱인 곳 김해 열대우림 체험농장 오픈 초창기에 예약제인줄 모르고...
ღ(2025-12-27 23:01:00)

-
받아 솔직하게 작성한 후기입니다. 안녕하세요 수브로맘입니다🤟🏻 비 오는 날에도, 무더운 날에도 걱정 없는 실내 체험 장소 찾고 계신가요? 김해 열대우림 체험농장은 아이들이 파충류 체험, 식물 관찰, 동물 먹이주기, 텃밭 체험 등 다양한 프로그램을 즐길 수 있는 실내 체험형 농장이에요. 게다가 카페 공간까지...
댕청맘 daily :)(2025-06-29 22:05:00)

-
300번길 154 ☎️ 0507-1486-1681 🅿️ 주차: 열대우림 옆 자갈주차장 열대우림 체험농장 이용방법 네이버예약으로 이용일 전 우선예약을 해야 해요. 열대우림 체험농장 : 네이버 방문자리뷰 412 · 블로그리뷰 53 m.place.naver.com 성인 수, 아이 수에 맞추어 예약을 하면 되고 예약확정 후 결제는 현장에서 하면 되요...
썸머다니의 모든 날(2025-09-01 14:22:00)

-
안녕하세요. 오늘은 남편이 당직하는 날이에요... 독박 육아 당첨 ㅠㅠㅠ 그래서 오늘은 친구와 땔구와 열대우림 농장을 다녀왔어요. 심심한 땔구를 위해 출바알~ [주소참고] 열대우림 체험농장 경상남도 김해시 호계로300번길 154 주차장은 건물 바로 옆 큰 주차장이 있습니다. 저는 주말에 갔더니 주차장에 자리가...
아오리네(2025-07-20 23:58:00)

-
이동했답니다 한번쯤은 방문하기 좋은 듯요 !! #김해 #열대우림 #열대우림체험농장 #열대우림현장대기 #파충류체험 #파충류카페 #파충류농장 #도마뱀체험...#김해동물체험 #김해파충류 #김해가볼만한곳 #김해나들이 #김해농장 #김해체험농장 #김해아기랑 #창원아기랑 #창원근교 #김해삼정동 #내돈내산 #방문후기
심쿵토리 ♡⁼(2025-10-12 16:25:00)

-
좋은 자리부터 빨리 차요. 👉 비교적 한산한 시간대 방문 추천 ‼️ Tip ‼️ 체험농장은 예약이 필수에요. 타임은 11시, 1시, 3시 이렇게 있어요. 저희는 1시 예약...있으면 지루해할 수도 있어요.😂 💡 총정리 (재방문의사?) ✔ 김해 열대우림 카페는 공간 만족도 높음 ✔ 김해 아이랑 카페 찾는다면 무난한 선택 ✔ 주차 편한...
내가 살아가는 이야기(2026-02-18 03:17:00)

일별 방문 통계
월별 방문 통계
날씨
리뷰 (0)
등록된 리뷰가 없습니다.
첨부파일

![우림농장 | [김해 삼정동] 부산 근교 실내에서 파충류를 만날 수 있는 곳 열대우림 체험농장(주차/가격/후기)](https://search3.kakaocdn.net/argon/130x130_85_c/8rXPLL9CFss)



![우림농장 | [내돈내산] 경남 김해 파충류 체험 가볼만한 곳 “열대우림 체험농장” 방문후기 (f.만4세)](https://search4.kakaocdn.net/argon/130x130_85_c/3kTwW844NYB)
